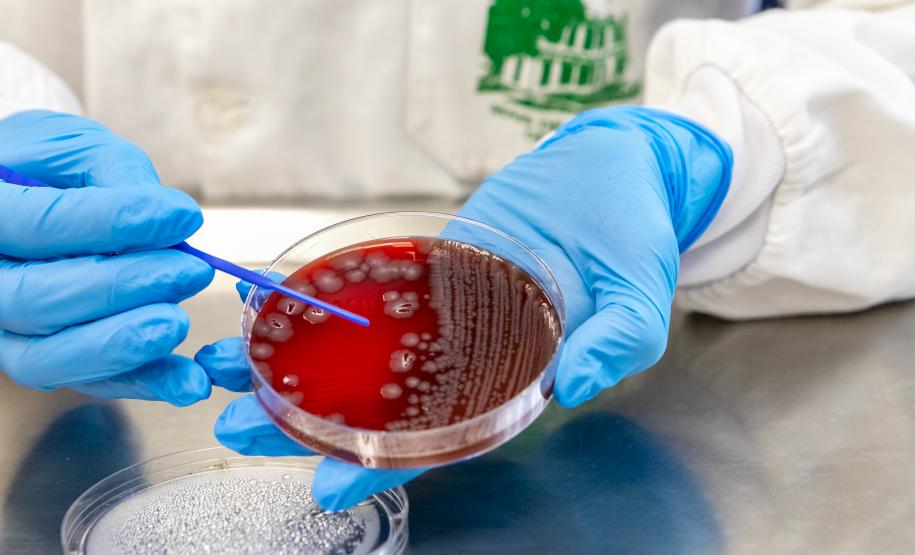
Doenças gastrointestinais: com 389 mil casos neste ano, Saúde alerta para ações de prevenção

Doenças gastrointestinais: com 389 mil casos neste ano, Saúde alerta para ações de prevenção 05/11/2024 - 17:35
A Secretaria da Saúde do Paraná (Sesa) orienta a população a ficar atenta aos cuidados para prevenir doenças diarreicas agudas (DDA), que atacam estômago e intestino e são causadas por microrganismos como vírus, bactérias e parasitas. Segundo levantamento feito pela pasta, de janeiro a outubro, o Paraná registrou 389.422 casos de diarreia na população em geral, sendo 56.839 em crianças de até cinco anos de idade. A atenção deve ser redobrada em crianças desta faixa etária.
Além dos casos, o Sistema de Informação de Agravos de Notificação (Sinan), plataforma oficial do Ministério da Saúde, também registrou 104 surtos da doença no Paraná. Os números de 2024 são maiores que os do ano passado inteiro, quando foram registradas 357.046 notificações e 67 surtos.
Considera-se surto quando duas ou mais pessoas apresentam a doença ou sinais e sintomas semelhantes, após ingerirem alimentos e/ou água da mesma origem, normalmente em um mesmo local, como restaurante ou festa, podendo ser também na residência, bairro, creche e local de trabalho. Outra situação é quando o município tem um padrão de casos por semana e ocorre o aumento.
As DDAs pertencem a um grupo de doenças infecciosas gastrointestinais que causam as gastroenterites (inflamação do trato gastrointestinal) e podem até levar a óbito, em casos extremos. A transmissão ocorre por consumo de água e alimentos contaminados, contato com outras pessoas doentes, através de mãos e objetos, e também pelo contato com animais.
“Essas são causas evitáveis, que englobam boas práticas, o cuidado e a prevenção, com a vacinação, especialmente das crianças”, afirma a diretora de Atenção e Vigilância em Saúde da Sesa, Maria Goretti Lopes. “É importante ressaltar que a vacinação não apenas reduz a incidência de casos graves, mas também pode salvar vidas”.
Segundo Maria Goretti, as características das doenças mostram a importância da integração dos profissionais da saúde pública nas diversas áreas, como o trabalho de laboratório, Vigilância Ambiental, Epidemiológica e Sanitária.
A vacinação contra o rotavírus, um dos principais agentes virais causadores das DDAs é recomendada para bebês. A vacina, disponível no Sistema Único de Saúde (SUS), tem o objetivo de proteger as crianças de desidratação. O esquema de vacinação é de duas doses exclusivamente por via oral, sendo a primeira aos 2 meses e a segunda aos 4 meses de idade com intervalo mínimo de 30 dias entre elas. A cobertura vacinal para este imunizante no Estado é de 90,22%.
SINTOMAS – Os casos de diarreia são caracterizados por um mínimo de três episódios em um período de 24 horas, evoluindo para aumento do número de evacuações e diminuição da consistência das fezes. Os sintomas também podem incluir náuseas, vômitos, dores abdominais e febre.
Geralmente, esses casos são autolimitados e duram cerca de 14 dias. No entanto, crianças desnutridas, com baixo peso e com condições crônicas de saúde têm maior risco de desenvolver casos mais graves.
PESQUISAS – O Laboratório Central do Estado (Lacen), unidade de referência para a saúde pública no Paraná, realiza a coprocultura e pesquisa molecular de bactérias e vírus em amostras de fezes de pacientes que atendam a definição de caso diarreico e estejam envolvidos na investigação de surto no Estado.
Em amostras clínicas (de pacientes) são pesquisados 11 microorganismos que causam esse tipo de doença, como Salmonella spp e Escherichia coli enteropatogênica (EPEC). Além disso, existe a investigação para cinco víru: rotavírus, norovírus, adenovírus, sapovírus e astrovírus.
“Na investigação de surtos é importante também avaliar a presença de toxinas. As informações dos envolvidos no surto, como qual alimento, quanto tempo para início dos sintomas e quais são eles, nos direcionam ao microrganismo a ser pesquisado e em qual amostra”, explica o diretor técnico da área ambiental do Lacen, André Dedecek.
DEMANDA – Além do número de casos e de surtos, há neste ano aumento expressivo no volume de exames realizados pelo Lacen/PR. No ano passado inteiro foram analisadas 1.551 amostras. Neste ano, apenas de janeiro a setembro, já houve 2.868 análises. E é possível que os números aumentem ainda mais com a chegada do verão, devido à maior movimentação de pessoas, especialmente em cidades litorâneas e turísticas, e também porque o calor prejudica a conservação de alimentos.
“A coleta e o transporte adequados são essenciais para manter a viabilidade e veracidade da análise. No Paraná, existe um cuidado permanente nessa área, reforçando sempre os trabalhos de pesquisa e análise”, complementa a diretora técnica do Lacen, Lavinia Arend.
Um dos exemplos do cuidado com essas doenças foi a capacitação de servidores que trabalham com dados referentes às DDAs. Em outubro, o aprimoramento ficou concentrado na 9ª Regional de Saúde de Foz do Iguaçu, que abrange nove cidades da região Oeste. Profissionais das Vigilâncias em Saúde dos municípios se debruçaram sobre a definição de caso, ficha de notificação, série histórica do Paraná, além de abordar temas relacionados ao diagnóstico laboratorial, transmissão hídrica e alimentar.